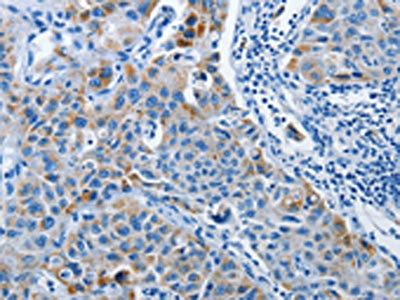

PRKG2 Antibody
-
中文名稱:PRKG2兔多克隆抗體
-
貨號:CSB-PA041842
-
規(guī)格:¥1100
-
圖片:
-
其他:
產(chǎn)品詳情
-
Uniprot No.:
-
基因名:
-
別名:CGK 2 antibody; cGK2 antibody; cGKII antibody; cGMP dependent protein kinase 2 antibody; cGMP-dependent protein kinase 2 antibody; cGMP-dependent protein kinase II antibody; KGP2_HUMAN antibody; PRKG 2 antibody; PRKG2 antibody; PRKGR2 antibody; Protein kinase; cGMP dependent; type II antibody; Type II cGMP dependent protein kinase antibody
-
宿主:Rabbit
-
反應(yīng)種屬:Human,Mouse,Rat
-
免疫原:Synthetic peptide of Human PRKG2
-
免疫原種屬:Homo sapiens (Human)
-
標(biāo)記方式:Non-conjugated
-
抗體亞型:IgG
-
純化方式:Antigen affinity purification
-
濃度:It differs from different batches. Please contact us to confirm it.
-
保存緩沖液:-20°C, pH7.4 PBS, 0.05% NaN3, 40% Glycerol
-
產(chǎn)品提供形式:Liquid
-
應(yīng)用范圍:ELISA,IHC
-
推薦稀釋比:
Application Recommended Dilution ELISA 1:1000-1:2000 IHC 1:15-1:50 -
Protocols:
-
儲存條件:Upon receipt, store at -20°C or -80°C. Avoid repeated freeze.
-
貨期:Basically, we can dispatch the products out in 1-3 working days after receiving your orders. Delivery time maybe differs from different purchasing way or location, please kindly consult your local distributors for specific delivery time.
-
用途:For Research Use Only. Not for use in diagnostic or therapeutic procedures.
相關(guān)產(chǎn)品
靶點詳情
-
功能:Crucial regulator of intestinal secretion and bone growth. Phosphorylates and activates CFTR on the plasma membrane. Plays a key role in intestinal secretion by regulating cGMP-dependent translocation of CFTR in jejunum. Acts downstream of NMDAR to activate the plasma membrane accumulation of GRIA1/GLUR1 in synapse and increase synaptic plasticity. Phosphorylates GRIA1/GLUR1 at Ser-863. Acts as regulator of gene expression and activator of the extracellular signal-regulated kinases MAPK3/ERK1 and MAPK1/ERK2 in mechanically stimulated osteoblasts. Under fluid shear stress, mediates ERK activation and subsequent induction of FOS, FOSL1/FRA1, FOSL2/FRA2 and FOSB that play a key role in the osteoblast anabolic response to mechanical stimulation.
-
基因功能參考文獻(xiàn):
- L-Arginine is a potential alternative to PKG II activation. PMID: 29401205
- Comparative analysis of the backbone hydrogen/deuterium exchange patterns in PKG II:8-pCPT-cGMP and previously reported PKG Ibeta:cGMP XN structures suggests that the ability of these agonists to activate PKG is related to how effectively they quench dynamics of the cyclic nucleotide binding pocket and the surrounding regions. PMID: 29517905
- the results indicated that PKG II could block c-Met activation via phosphorylating Ser985 PMID: 27147579
- PKG II inhibits EGFinduced activation of HER2 through binding with and causing threonine 686 phosphorylation of this oncogenic protein. PMID: 26676300
- The C-terminal cyclic nucleotide binding (CNB-B) domain of cGMP-dependent protein kinase II binds cGMP with higher affinity and selectivity when compared with its N-terminal CNB (CNB-A) domain. PMID: 26769964
- Han Chinese patients with rs10033237 polymorphism of cGKII/PRKG2 gene are more likely to suffer from gout. PMID: 25688884
- Our replication study suggests that cGKII is not involved in gout susceptibility. PMID: 24882840
- we determined a crystal structure of the PKG II LZ-Rab11b complex. The PKG II LZ domain presents a mostly nonpolar surface onto which Rab11b docks, through van der Waals interactions PMID: 25070890
- PKGII inhibits RhoA activity by binding to this small GTPase and causing phosphorylation at its Ser188 site. PMID: 24549567
- PKG II also inhibits the activation of the EGFR caused by diverse ligands of the receptor. PMID: 24534906
- type II cGMPdependent protein kinase prevented the EGF-induced phosphorylation/activation of ERK and JNK, but not the phosphorylation of p38MAPK induced by EGF. PMID: 22940826
- Downregulation of PKG2 was associated with malignant and benign breast tumors. PMID: 22791569
- The work presented here demonstrates a novel antiproliferative and prodifferentiation role for PKG2 in the colon. PMID: 22556146
- The results suggest that PKGII inhibits EGF-induced MAPK/JNK-mediated signal transduction and further confirmed that PKGII can block the activation of EGFR. PMID: 22427012
- PKG II inhibits the proliferation of gastric cancer cells through blocking EGF-triggered MAPK signal transduction. PMID: 22012247
- As an addition to PRKG2 and RASGEFIB genes, we propose to include BMP3 gene as the principal determinant of the observed common phenotype. PMID: 22303795
- Inhibition of cGMP-dependent protein kinase II by its own splice isoform PMID: 12054676
- results show that the fast phase of autophosphorylation of cGMP dependent protein kinase II has a small effect on its activity, whereas the secondary phase involving Ser126 phosphorylation may generate an active form PMID: 12764134
- Characterization of the 4q21 breakpoint revealed PRKG2 as the likely gene partner to PDGFRB in myeloproliferative disorders. PMID: 18262053
- Results suggest that the cGK II gene on chromosome 4q21 is most likely to harbour gout disease independently of hyperuricaemia and is inherited recessively. PMID: 18678579
- Regulation of epithelial sodium channels by cGMP/PKGII. PMID: 19359370
- PRKG2 inhibits cell proliferation, Sox9 expression and Akt phosphorylation in human glioma cell lines. PMID: 19543319
顯示更多
收起更多
-
亞細(xì)胞定位:Apical cell membrane; Lipid-anchor.
-
蛋白家族:Protein kinase superfamily, AGC Ser/Thr protein kinase family, cGMP subfamily
-
組織特異性:Highly concentrated in brain, lung and intestinal mucosa.
-
數(shù)據(jù)庫鏈接:
Most popular with customers
-
-
YWHAB Recombinant Monoclonal Antibody
Applications: ELISA, WB, IHC, IF, FC
Species Reactivity: Human, Mouse, Rat
-
Phospho-YAP1 (S127) Recombinant Monoclonal Antibody
Applications: ELISA, WB, IHC
Species Reactivity: Human
-
-
-
-
-